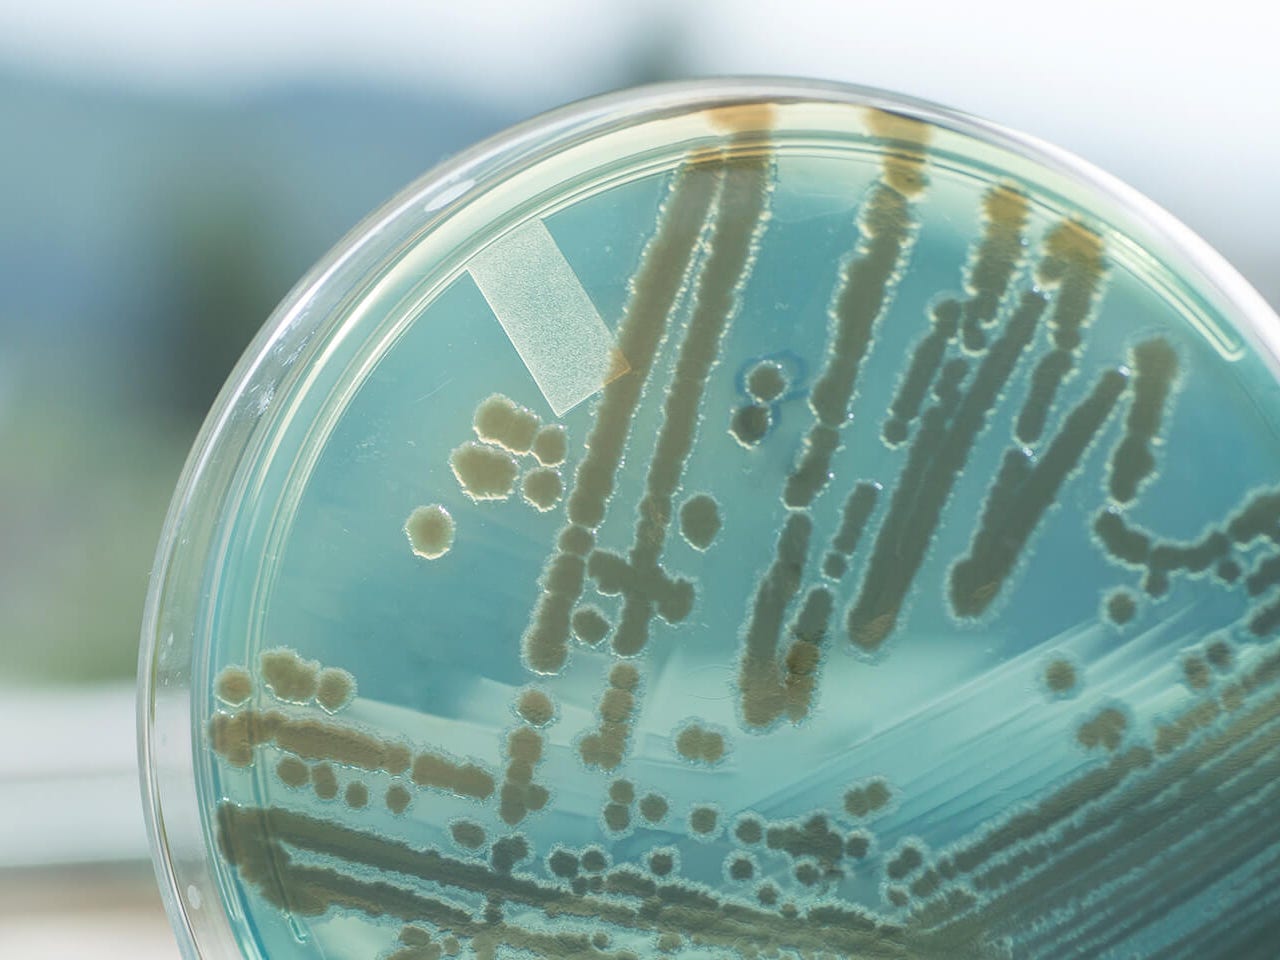

Filtration success stories from every industry
Explore our showcase of filtration success stories from across industries. Whether maximizing water reuse, safeguarding cleanroom air, or boosting energy efficiency in critical processes, these credentials highlight how our solutions deliver value, reliability, and measurable impact for customers around the world.
Our filtration success stories for cleaner mobility & industries

Air cleaner – CNHTC trucks
Tailored air cleaner system for CNHTC trucks delivered high dust holding capacity, low pressure drop, durability, and longevity in challenging mining environments.

Oil filter – Paccar MX‑13 engines
MANN+HUMMEL's integrated oil filter module for Paccar MX-13 engines ensures filtration efficiency and reliability for heavy-duty vehicle applications.

Air cleaner – Mercedes‑Benz engines
An oval air cleaner system was engineered for the Mercedes-Benz trucks Antos, Actros and Arocs, aligning durability with high performance for automotive filtration.

Oil filter – FPT Industrial
High-performance oil filter modules offer tailored, reliable filtration solutions for FPT Industrial engines and demanding applications.

Air filters – Daimler & Mercedes
MANN+HUMMEL supplies premium air filters for Daimler and Mercedes-Benz, supporting superior engine protection and performance across automotive segments.
Our filtration success stories for cleaner air

HVAC filtration – Heathrow airport
MANN+HUMMEL delivered energy-efficient HVAC filtration at Heathrow Airport, improving air quality, sustainability, and operational efficiency while lowering costs via streamlined maintenance and optimized filter management.

Air filtration – Pasta production
Aircube Eco filters in Italian pasta production reduced energy use by 29%, doubled filter life, and saved €37,000 per year – improving air quality and operational cost-effectiveness.

LTF ceiling – Laminar air flow
LTF ceiling systems with HEPA filters lowered germ loads in operating rooms, supporting top cleanroom standards, reduced noise, and safety for patients and staff in hospitals.

Energy savings in food production
A confectionery producer in Germany saved over 440,000 kWh and €110,000 annually by switching to Airpocket Eco filters, enhancing energy efficiency without sacrificing air quality.

A+ filters – Energy efficiency
MANN+HUMMEL A+ filters save up to 41% more energy versus standard filters, cutting costs and emissions, extending filter lifespan, and helping customers meet environmental targets.

Clean air in optical clean rooms
Installation of Nanoclass FFU Select units improved air purity, reduced failure risks, and lowered noise and energy consumption in optical component cleanrooms for semiconductor and aerospace industries.

Air filtration – Pharma production
A German pharmaceutical company cut annual energy bills by almost €20,000 and doubled filter change intervals by upgrading to Airpocket Eco filters, achieving better air quality and compliance.
Our filtration success stories for cleaner water

Dairy ultrafiltration – 10 kDa membrane
Field-tested TRISEP 10kUF membrane increases permeate flow by 20–40% in dairy ultrafiltration, maintaining protein retention and stable performance across whey and milk applications.

Advancing MBR technology
BIO-CEL L+480 with UV400 membrane enabled a West Coast casino to expand wastewater reuse, boosting treatment capacity, efficiency, and compliance with California Title 22 standards.

Trisep SBNF – NOM removal
TRISEP SBNF nanofiltration membranes remove color and organic matter, reliably producing high-quality drinking water in small communities from challenging surface water sources.

RO & UF for boiler feed water
Integrated PureULTRA II UF and MICRODYN RO deliver chemical-free, high-purity boiler feed water for sugar production, reducing contaminants and simplifying operations in Brazil’s sugar industry.

X‑20 RO for wastewater reuse
TRISEP X-20 RO membranes convert high-fouling municipal wastewater into high-quality irrigation water; system achieves long element life and permeate conductivity under 100 µS/cm.

X‑20 RO for oil refinery
Southeast Spain refinery adopts TRISEP X-20 RO membranes for boiler water reuse, achieving 75% recovery in the main system and reliable, long-term high-permeate quality.

X‑20 RO for tertiary reuse
Municipal plant’s tertiary RO with X-20 elements produces consistent high-quality water for reuse. Elements operate beyond standard lifetimes, reducing maintenance and long-term costs.
BIO‑CEL MBR – Micropollutant removal
BIO-CEL MBR modules provide efficient removal of micropollutants, microplastics, and bacteria from wastewater, securing regulatory compliance and improved water reuse quality.

BIO‑CEL MBR – Dundrum retrofit
BIO-CEL MBR modules successfully replaced older Kubota membranes, enhancing performance, reducing energy and maintenance needs, and extending operational efficiency in wastewater treatment plants in Northern Ireland.

UF – Coal-fired power plant ash pond
iSep 500 UF system treats ash pond water from coal power plants, delivering reliable solids removal and contributing to efficient, compliant water reuse and environmental protection.

BIO‑CEL MBR – HaSolelim WWTP
BIO-CEL XL MBR modules at HaSolelim municipal WWTP in Israel provided high quality effluent for irrigation, reduced energy demand, and lowered operating costs with reliable, self-healing membranes.

BIO‑CEL MBR – Konacik WWTP
Konacik WWTP in Turkey uses 12 BIO-CEL 400 MBR modules to achieve high quality irrigation effluent with reduced energy use and easier maintenance via self-healing membranes and efficient backwash.

MBR – Petroleum wastewater treatment
14 BIO‑CEL® XL MBR modules in a Shandong petroleum plant in China cut COD, BOD, TSS, nutrients, oil, and turbidity, exceeding strict permit limits, boosting capacity, and ensuring stable, compliant performance.

BIO‑CEL & RO – Food processing
A European food plant uses BIO-CEL MBR and MICRODYN RO to recycle high-starch wastewater for process water, achieving >97% COD and >93% dissolved solids reduction while lowering operational costs.

UF – High‑turbidity river water
iSep 500 UF modules effectively treat river water in the U.S. with high turbidity, delivering reliable solids and bacteria removal for safe downstream use and environmental compliance.

UF – MBR peak flow management
iSep 500 UF system accommodates peak wastewater flows in MBR facilities in California, ensuring robust filtration performance and stable effluent quality during fluctuating conditions.

UF – Produced water treatment
iSep 500 UF modules provide efficient pretreatment for produced water, enabling contaminant removal and supporting water reuse in industrial processes in the Midwest Region of the U.S.